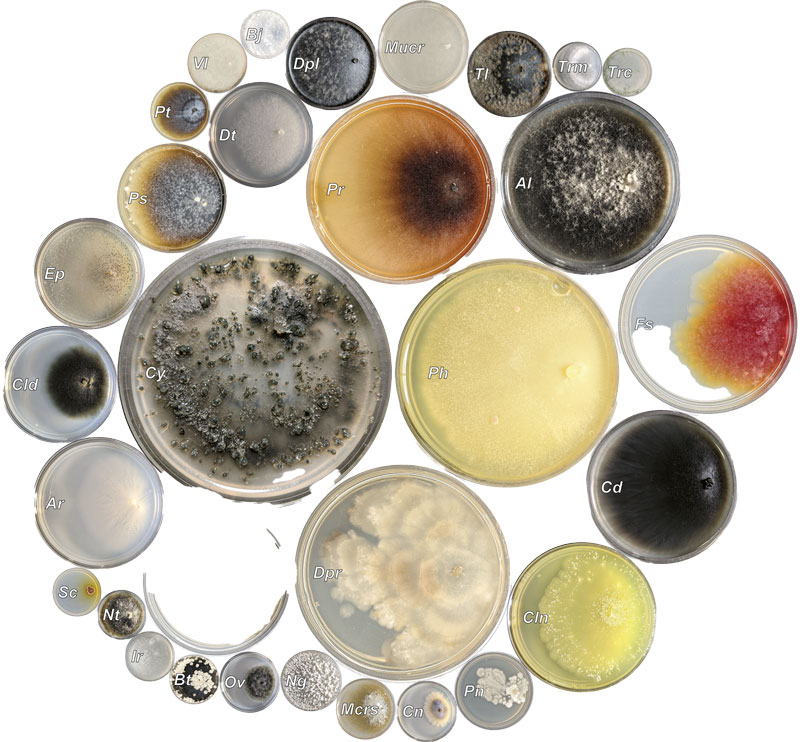

Holzkrankheiten der Weinrebe verkürzen die produktive Lebensdauer von Weinbergen erheblich. Die weltweiten Einbußen gehen in die Milliarden. Im ersten Teil der Serie Rebschnitt und Holzkrankheiten beschreibt Martin Ladach vom Dienstleistungszentrum Ländlicher Raum (DLR) Neustadt die wichtigsten Holzkrankheiten an Reben und welche nennenswerten Schäden sie verursachen.
Mehr dazu im DEUTSCHEN WEINMAGAZIN Ausgabe 22 vom 25.10.2025, Seite 32.